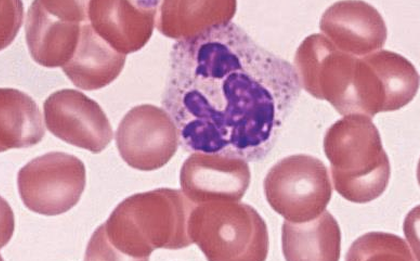
<p>Neutrophils</p>
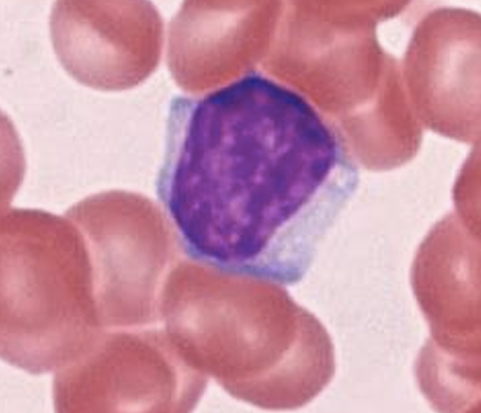
<p>T Lymphocyte</p>

A&P 2 Blood cells and groups
1/93
There's no tags or description
Looks like no tags are added yet.
Name | Mastery | Learn | Test | Matching | Spaced | Call with Kai |
|---|
No analytics yet
Send a link to your students to track their progress
94 Terms
About 5 liters
Approximately how much blood is in the human body?
A fluid connective tissue.
Blood is classified as what type of tissue?
Approximately 8%
About what percentage of total body weight does blood make up?
Blood is constantly moving through arteries, veins, and capillaries and does not normally leave the vessels.
What does it mean that blood “always circulates through blood vessels”?
Continuous circulation allows blood to deliver oxygen and nutrients and remove wastes from tissues efficiently.
Why is it important that blood continuously circulates?
Plasma, erythrocytes (red blood cells), and leukocytes (white blood cells).
What are the three main components of blood?
About 55%.
What percentage of whole blood is plasma after centrifugation?
The buffy coat is the thin middle layer that contains leukocytes and platelets.
What is the buffy coat and what does it contain?
1%
What percentage of whole blood is buffy coat after centrifugation?
liquid extracellular matrix of blood
What is plasma?
It include cells and cell fragments suspended in plasma
What is the formed elements?
44%
What percentage of whole blood is hematocrit (bottom layer) after centrifugation?
Composed of erythrocytes
What does the bottom layer consist of?
exchanging gases
distributing solutes
performing immune functions
maintaining body temperature
functioning in blood clotting
preserving acid-base homeostasis
stabilizing blood pressure
What are the blood functions? (7 functions)
pale yellow fluid that makes up about 55% of total blood volume
What is plasma?
90% water (factor in determining viscosity of blood), 8% plasma protein, and 2% several small molecules dissolved in water portion of plasma
What is plasma consist of and their %?
albumin
immune proteins
transport proteins
clotting proteins
List the plasma proteins? (4)
a plasma protein synthesized in liver; responsible for blood’s colloid osmotic pressure; draws water into blood by osmosis
What is albumin?
a plasma protein also known as antibodies; made by leukocytes, components of immune system
What are immune proteins (gamma-globulins)?
a plasma protein that bind to lipid-based molecules (fats and steroids) that otherwise are incompatible with mostly water-based plasma
What are transport proteins?
a plasma protein that stop bleeding from injured blood vessels by forming a blood clot with assistance from platelets
What are clotting proteins?
A biconcave disc that is concave on both sides. This shape increases surface area for gas exchange (facilitate their transport of oxygen and carbon dioxide).
Describe the shape of red blood cells and why it’s important.
nucleus (they are anucleate), lost nucleus during maturation and lack other cellular organelles
Mature red blood cells don’t have ____
To make more room for hemoglobin. osing the nucleus allows RBCs to carry more oxygen
Why do mature red blood cells lack a nucleus?
Hemoglobin is a protein in RBCs that binds and transports oxygen and carbon dioxide.
What is hemoglobin and what does it do?
250 million
Each RBC contains about ____ hemoglobin molecules.
Hemoglobin releases oxygen in tissues where the oxygen concentration is low.
When does hemoglobin release oxygen to body tissues?
Hemoglobin can bind to carbon dioxide (CO₂) when oxygen levels are low.
Besides oxygen, what other gas can hemoglobin bind to and under what condition?
relatively short, ranging from 100–120 days
What is an erythrocyte life span?
the process of producing new red blood cells (erythrocytes).
What is erythropoiesis?
In the sinusoids of the spleen.
Where are old erythrocytes typically removed from circulation?
Macrophages
Which cells are responsible for digesting old red blood cells?
Amino acids, iron ions, and heme.
Into what components is hemoglobin broken down after RBC death?
Leukocytes are larger than RBCs and contain a prominent nucleus.
How do leukocytes differ structurally from erythrocytes?
They adhere to blood vessel walls and then squeeze between endothelial cells to enter tissues.
How do leukocytes move from the bloodstream into surrounding tissues?
Granulocytes contain cytoplasmic granules that are released when activated, while agranulocytes lack visible granules.
What is the main difference between granulocytes and agranulocytes?
They have a single nucleus composed of multiple connected lobes.
What structural feature makes granulocytes easy to distinguish from other leukocytes?
General lysosomal granules and granules unique to each granulocyte type.
What types of granules are found in all granulocytes?
They are classified based on the color of their granules—light lilac, dark purple, or red.
How are the three types of granulocytes classified?
50–70%.
What percentage of the white blood cell population is made up of neutrophils?
They have 3–5 variably shaped lobes (polymorphonuclear) and a light lilac–stained cytoplasm because their granules absorb both dyes.
How can neutrophils be identified based on their nucleus and staining characteristics?
They are active phagocytes that ingest and destroy bacterial cells.
What is the primary function of neutrophils in the immune system?
Neutrophils
What leukocyte is this?
They have a bilobed nucleus and stain brick red or crimson due to uptake of the eosin (acid) dye.
How can eosinophils be identified by their nucleus and staining color?
They ingest foreign molecules and respond to parasitic worm infections and allergic reactions.
What are the main immune functions of eosinophils?
2–4%; their granules contain enzymes and toxins specific to parasites and chemicals that promote inflammation.
What percentage of the white blood cell population is made up of eosinophils, and what do their granules contain?

eosinophils
What leukocyte is this?
0.5–1%, making them the least common leukocyte.
What percentage of the white blood cell population is made up of basophils?
They have an S-shaped nucleus and stain dark purple due to uptake of methylene blue (basic) dye.
How can basophils be identified based on nucleus shape and staining color?
The granules contain chemicals that mediate inflammation.
What is the primary function of basophil granules?

Basophils
What leukocyte is this?
Lymphocytes
Which type of leukocyte is classified as an agranulocyte and includes B and T cells?
They have a large, spherical nucleus with a thin light-blue rim of cytoplasm.
How do lymphocytes appear structurally under the microscope?
They are the second most common leukocyte in the blood.
How common are lymphocytes compared to other white blood cells?
they produce antibodies that bind to and help remove specific antigens from tissues.
What is the main immune function of B lymphocytes when they are activated?
T lymphocytes are activated by specific antigens and recognize them using membrane-bound receptors.
How are T lymphocytes activated and how do they recognize antigens?
T lymphocytes do not produce antibodies, whereas B lymphocytes do.
How do T lymphocytes differ from B lymphocytes in terms of antibody production?
They activate other immune system components and directly destroy abnormal cells (such as cancer or virus-infected cells), and they make up about 25% of WBCs.
What are the main functions of T lymphocytes and what percentage of the WBC population do they make up?
T Lymphocyte
What leukocyte is this?
Monocytes are the largest leukocytes and have a large U-shaped nucleus surrounded by light blue or purple cytoplasm.
How can monocytes be identified based on size and nucleus shape?
They circulate only briefly in the bloodstream before entering tissues.
How long do monocytes circulate in the blood?
They become macrophages, which phagocytose dead and dying cells, bacteria, antigens, and cellular debris.
What do monocytes become once they leave the bloodstream, and what is their main function?
They display phagocytosed antigens to other leukocytes to activate immune responses and make up 3–8% of the WBC population.
How do monocytes/macrophages help activate the immune system, and what percentage of WBCs do they represent?

Monocyte
What leukocyte is this?
50-70
what percentage of WBCs do neutrophils represent?
2-4
what percentage of WBCs do eosinophils represent?
0.5-1
what percentage of WBCs do basophils represent?
25-45
what percentage of WBCs do lymphocytes represent?
3-8
what percentage of WBCs do monocytes represent?
Platelets are small cell fragments surrounded by a plasma membrane.
What are platelets and how are they structurally described?
Platelets are involved in hemostasis, the process that stops blood loss from injured blood vessels.
What is the primary function of platelets in the body?
Platelets lack nuclei and most organelles found in whole cells.
How do platelets differ from most whole cells?
Platelet granules contain clotting factors and enzymes, which are essential for blood clot formation.
What do platelet granules contain and why are they important?
Erythrocytes (red blood cells).
Which formed element is responsible for transporting oxygen and carbon dioxide in the blood?
Neutrophils.
Which leukocyte functions primarily to phagocytize bacteria?
Eosinophils.
Which white blood cell kills parasitic worms and is involved in allergic reactions such as asthma?
Basophils.
Which leukocyte releases histamine and other mediators of inflammation and contains heparin, an anticoagulant?
Lymphocytes.
Which agranulocyte mounts an immune response through direct cell attack or antibody-mediated immunity?
Monocytes.
Which white blood cell performs phagocytosis and develops into macrophages in tissues?
Platelets.
Which formed element seals small tears in blood vessels and is essential for blood clotting?
Surface antigens on RBCs determine a person’s blood group by identifying the cell as “self” or “foreign” to the immune system.
What role do surface antigens on red blood cells play in determining blood type?
he ABO and Rh blood group systems; they are important because incompatibility can cause dangerous immune reactions during transfusions.
What are the two most clinically important blood group systems, and why are they important?
Agglutination is the clumping of RBCs caused by antibodies binding to antigens; it can lead to erythrocyte destruction (hemolysis).
What is agglutination, and why is it dangerous during incompatible blood transfusions?
A severe immune reaction in which recipient antibodies attack donor RBC antigens, causing agglutination, hemolysis, shock, renal failure, and possibly death.
What is an acute hemolytic (transfusion) reaction?
Antibodies are used to bind to specific antigens on erythrocytes to identify blood type.
What is the purpose of using antibodies in laboratory blood typing?
Antibodies are proteins that bind to foreign antigens.
What are antibodies, and what do they bind to?
The red blood cells clump together, a process called agglutination.
What happens when antibodies bind to surface antigens on red blood cells?
Agglutination promotes erythrocyte destruction (hemolysis).
Why is agglutination dangerous to erythrocytes?